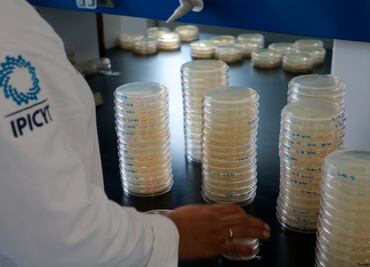

Tendencias20/11/2019
Estima investigadora que suelo es una biofarmacia productora de antibióticos naturales
Un 60% de los antibióticos en el mercado provienen de fuentes naturales.
07 / diciembre / 2025 | 20:44 hrs.
Un 60% de los antibióticos en el mercado provienen de fuentes naturales.